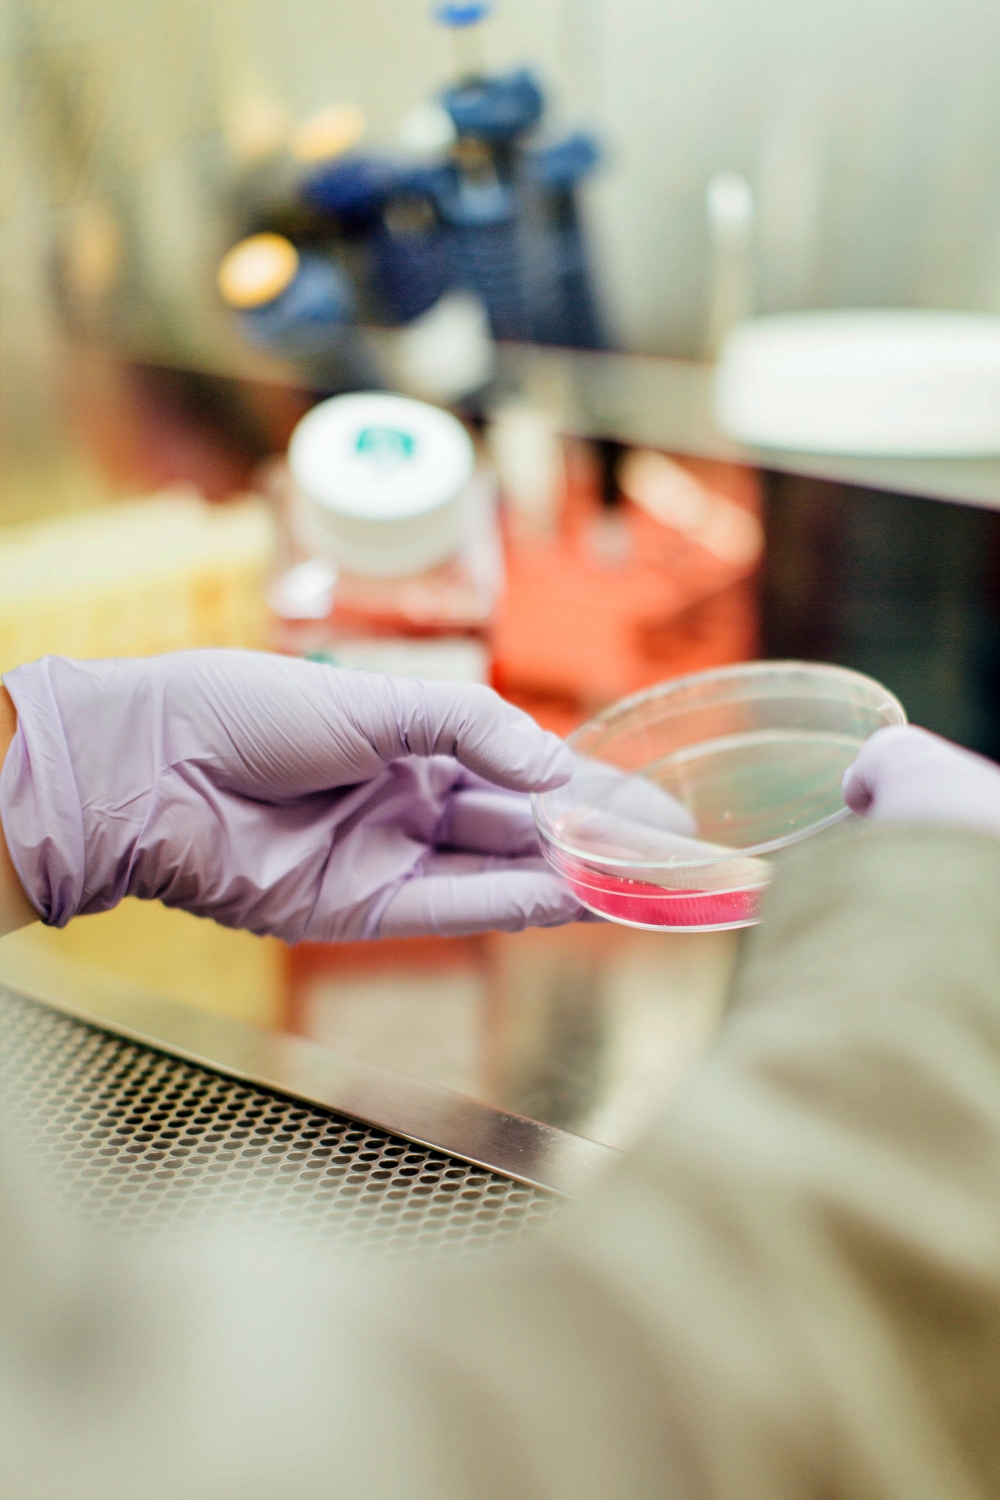

Dr n. med. Elżbieta Kortyczko: dziecko ma prawo urodzić się jako owoc miłości
„Jeżeli mamy do czynienia z nowym życiem, to czy możemy je zabijać, czy możemy nim manipulować, czy mamy prawo poczętego człowieka zamrażać?” – to są pytania, które, zdaniem dr nauk medycznych Elżbiety Kortyczko, powinny rodzić się w zetknięciu z nowoczesnymi technikami zapłodnienia pozaustrojowego. Prezes Katolickiego Stowarzyszenia Lekarzy Polskich zaznacza, że prawdę o procedurze in vitro, bez względu na to, jak bardzo ukrytą, należy starać się wydobywać na światło dzienne.
Jak podkreśla neonatolog, procedura zapłodnienia pozaustrojowego realizowana jest w warunkach nienaturalnych. „Choć zespoły pracujące w klinikach starają się stwarzać warunki bardzo zbliżone do naturalnych, to jednak sam proces zapłodnienia odbywa się na szkle, na szalkach laboratoryjnych, w inkubatorze.

fot. Radio eM
„Bardzo nikła jest społeczna świadomość, że istota zapłodnienia in vitro polega właśnie na łamaniu naturalnych barier (in vitro to gwałt na naturze), uniemożliwiających zapłodnienie w przypadkach, które skutkowałyby różnorakimi defektami genomu” – cytuje za prof. Andrzejem Lewandowiczem.
„Publikacje światowe, w tym także kliniki zajmujące się tą procedurą, wskazują na zagrożenia dla matki i dziecka, jakie niesie ta metoda” – zauważa.
Zwraca uwagę, że zaburzenia chromosomowe na skutek procedury IVF są większe aniżeli w ogólnej populacji. „W ogólnej populacji też się zdarzają, jednak tutaj są większe. Większa jest częstość występowania wad serca, wad przewodu pokarmowego, zarośnięcia przełyku, odbytu, rozszczepu wargi, podniebienia. I jest to częstotliwość dwa lub więcej razy większa, aniżeli w całej populacji. Częstsze są defekty układu moczowo-płciowego u chłopców, więcej zabiegów chirurgicznych do 5. roku życia, więcej jest przypadków śmierci okołoporodowej, wcześniactwa. Większe jest ryzyko martwego urodzenia, niskiej masy urodzeniowej lub gigantyzmu płodowego. Literatura fachowa mówi też o większej częstości mózgowego porażenia dziecięcego” – wylicza.

Dodaje, że odnotowano w historii zgony kobiet, które uczestniczyły w procedurze in vitro. Miało to związek m.in. z powikłaniami będącymi rezultatem hiperstymulacji jajników.
Według pediatry z Kliniki Intensywnej Terapii i Patologii Noworodka Górnośląskiego Centrum Zdrowia Dziecka w Katowicach, dziecko ma prawo urodzić się jako owoc miłości, a nie jako przedmiot chęci posiadania.
„To jest uprzedmiotowienie człowieka, a człowiek jest podmiotem. Każdy człowiek ma godność wrodzoną: od momentu poczęcia. Życie zaczyna się w momencie połączenia materiału genetycznego ojca i matki. Wpisane jest w żywą materię. Nie ma życia przedludzkiego. To nie jest zlepek komórek czy tkanka, jak możemy usłyszeć. To jest nowy człowiek” – podkreśla. Wszystkie dzieci poczęte, także te poczęte in vitro, także te zamrożone w ciekłym azocie, mają niezbywalną godność osoby ludzkiej.
Przyznaje jednocześnie, że wielu rodziców ogromnie cierpi z powodu niepłodności, niemożności doczekania się potomstwa. „Jednak cel nie może uświęcać środków. Czy my możemy produkować człowieka? Bo na tym polega technika in vitro – na doprowadzeniu do połączenia komórki jajowej i plemnika na szkle, żeby w tych zespolonych gametach doszło do fuzji materiału genetycznego i żeby powstał nowy człowiek” – zauważa i za Janem Pawłem II powtarza, że z procedurą in vitro związana jest wielka niesprawiedliwość nie do naprawienia. Oto miliony istot ludzkich zostaje zamrożonych w temperaturze ciekłego azotu (minus 196 stopni Celsjusza).
„Bardzo współczujemy tym małżeństwom, które nie mogą się doczekać potomstwa, ale nie tędy droga. Czy my możemy stawiać się w miejscu Boga?” – pyta i zauważa, że zaburzenia genetyczne często ujawniają się dopiero w trzecim pokoleniu. Jak przyznaje, dotąd obserwacje konsekwencji, jakie ma procedura in vitro na zdrowie dzieci nie są długie. Przypomina, że pierwsze na świecie dziecko z probówki Louise Brown urodziła się w 1978, a w Polsce 1987.
Dr Elżbieta Kortyczko uważa, że duże szanse na naturalne urodzenie dziecka daje dziś naprotechnologia. Zwraca uwagę, że dr. Tadeusz Wasilewski, znany w Polsce propagator naprotechnologii, kiedyś pracował w klinice in vitro i należał do najlepszych specjalistów tej techniki zapłodnienia. Wyjaśnia, że twórcą naprotechnologii jest prof. Thomas W. Hilgers z USA. Kluczem do skutecznego leczenia niepłodności było dla niego rozeznanie naturalnego rytmu płodności kobiety. Ma to ułatwić tzw. model Creightona, opierający się kilkumiesięcznej obserwacji cyklu kobiety.